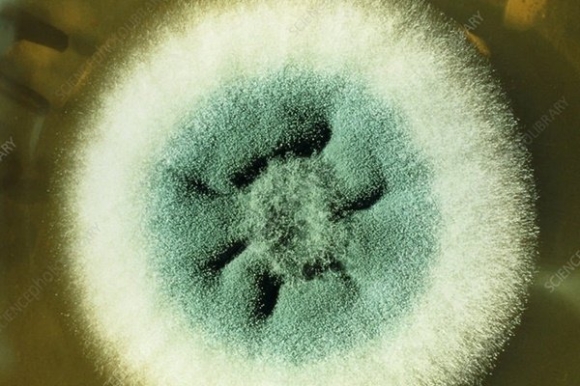
1 Loai Nam Rinh Rap Benh Nhan Covid 19 Co The Da Giet Chet Hang Ngan Nguoi

Nấm Aspergillus fumigatus được quan sát bằng kính hiển vi. Ảnh: sciencephoto.com
Loại nấm được đề cập ở đây là Aspergillus fumigatus. Chúng có mặt ở xung quanh chúng ta, trong không khí, đất, thức ăn và trong vật chất hữu cơ đang thối rữa như phân bón. Nó cũng đã được tìm thấy trong bồn hoa của các bệnh viện. Chúng trông như một lớp rêu mốc màu xám nhăn nheo bám trên mặt tường ẩm ướt và lây lan cho con người qua các bào tử cực nhỏ.
Báo Daily Mail của Anh đưa tin Aspergillus fumigatus là loại nấm chuyên tấn công những người có hệ miễn dịch bị suy yếu nghiêm trọng do bệnh tật. Khi xâm nhập vào con người, nhiễm trùng có thể phát triển thành bệnh aspergillosis xâm lấn phổi, sau đó lây lan đến da, não, tim hoặc thận. Ở đó, nấm có thể phát triển thành một cục to bằng quả bóng tennis và cực kỳ khó diệt trừ.
Vô số bệnh nhân COVID-19 được đưa đến khoa chăm sóc tích cực trong tình trạng khó thở sau đó đã bị nhiễm aspergillus, song các nhà khoa học chưa thể thống nhất được chính xác số lượng người bị nhiễm nấm. Một thông cáo báo chí của các nhà điều tra tại Đại học Exeter hồi tháng 3 cho biết con số này cao tới 1/3. Trong khi đó, nghiên cứu quốc tế công bố trên tạp chí “Emerging Infectious Diseases” vào tháng 10 lại chỉ ra tỷ lệ là 1/6.
Tại sao lại có sự chênh lệch lớn đến vậy? Theo một trong những chuyên gia hàng đầu của Anh, ông David Denning, Giáo sư về các bệnh truyền nhiễm tại Đại học Manchester, sự chênh lệch trên phụ thuộc nhiều vào việc các bác sĩ lâm sàng có đủ giỏi để chẩn đoán hay không cũng như nhận thức của họ về căn bệnh này. “Nếu không thử kiểm tra, bạn sẽ không phát hiện được. Có lẽ nhiều bệnh nhân trong khu chăm sóc đặc biệt đã tử vong vì Aspergillus fumigatus mà không ai hay biết”, ông Denning nói.
Phương pháp điều trị tiêu chuẩn là sử dụng các loại thuốc kháng nấm mang tên azole.
Giáo sư Denning cho biết: “Nếu được sử dụng đúng lúc, chúng có thể chữa khỏi cho 75% bệnh nhân mắc bệnh aspergillus”. Tuy nhiên, nấm Aspergillus đang phát triển khả năng chống lại những thứ này. Điều này chủ yếu là do việc sử dụng quá nhiều azole cả trong y học và nông nghiệp. Giáo sư Denning cho hay tình trạng này đã tạo điều kiện để nhiều chủng vi nấm độc lực mạnh tiến hóa khả năng kháng thuốc.

Nấm Aspergillus chủ yếu tấn công vào phổi của bệnh nhân. Ảnh: Getty Images
Một giả thuyết được nêu trên tạp chí Microbial Ecology tháng trước cho rằng cả virus SARS-CoV-2 và nấm Aspergillus đều tấn công vào các phân tử giống nhau trong phổi. Vì vậy, khi COVID-19 đã chọc thủng được hàng phòng ngự của hệ miễn dịch, nấm Aspergillus có thể dễ dàng tiến vào.
Theo các chuyên gia, tỷ lệ tử vong ở bệnh nhân COVID-19 bị nhiễm nấm là rất cao, lên đến 70%. Do vậy, họ đã sáng chế một kỹ thuật mới để dễ dàng chẩn đoán người nhiễm nấm Aspergillus. Cụ thể, họ tiêm một loại kháng thể được thiết kế đặc biệt để liên kết với các phân tử aspergillosis trong phổi của những người bị nhiễm bệnh.
Kháng thể này có yếu tố chất phóng xạ nên có thể quan sát được trên phim chụp X-quang phổi. Tuy nhiên, đây chỉ là một chẩn đoán. Vẫn tồn tại một thực tế là nhiễm trùng do nấm Aspergillus có khả năng xâm lấn cao và khó điều trị. Theo các chuyên gia, tốt nhất người dân nên tiêm vaccine ngừa COVID-19 để tránh rơi tình thế “nguy hiểm kép” do virus SARS-CoV-2 và nấm Aspergillus gây ra.
Theo Báo Tin tức

